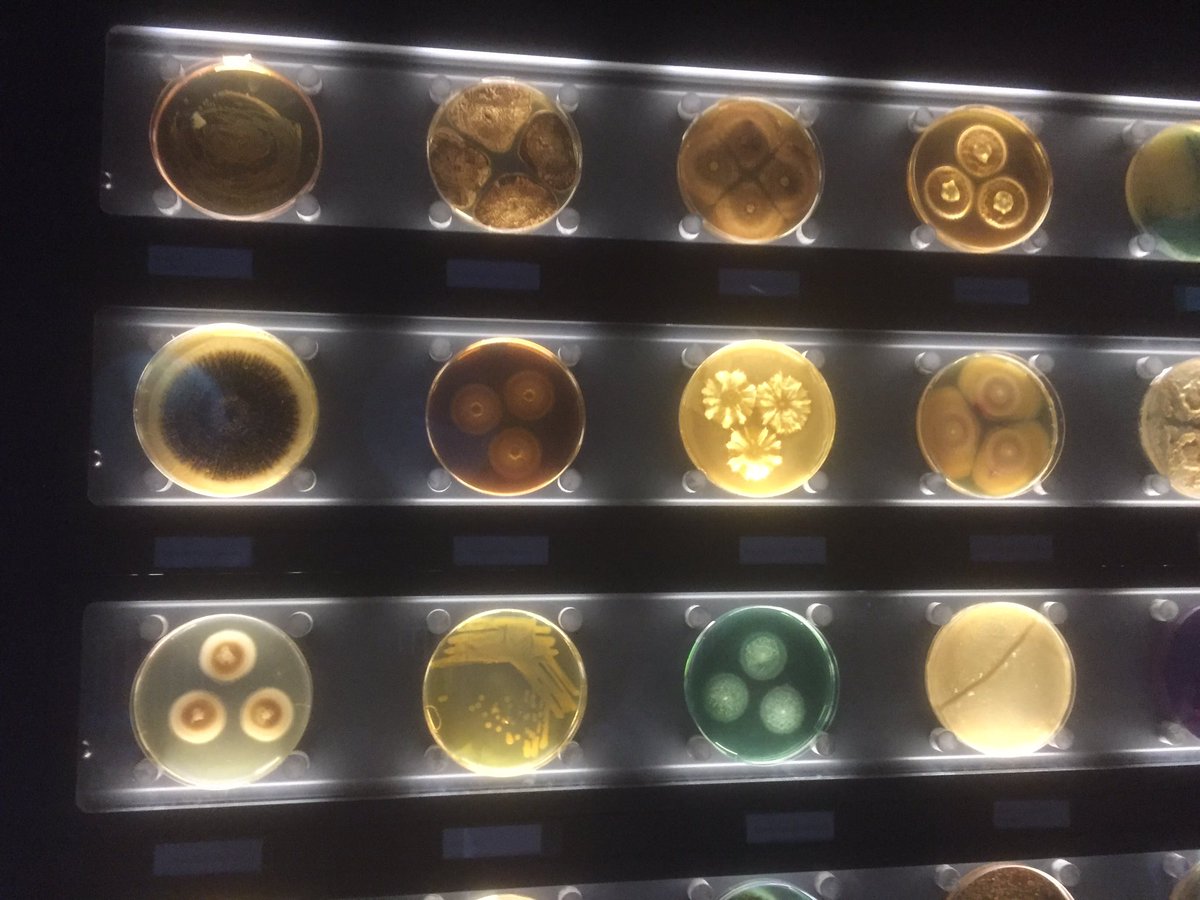

Cam Botanic Comms
@cambotaniccomms
News, events & research from Cambridge University's Botanic Garden - over 8000 species from all over the world in one stunning garden. facebook.com/CambridgeUnive…
ID: 2291062285
http://www.botanic.cam.ac.uk 14-01-2014 11:57:16
108 Tweet
383 Takipçi
349 Takip Edilen



It's the first day of #Spring. Professor Nick Davies teaches us to impersonate a cuckoo Cam Botanic Garden




Opening of #AIC CambPlants Cam Botanic Comms - vote of thanks to @S_D_Richardson from Swansea University


Day 1 #CarolsChelsea2016 Leaving my beautiful garden for #RHSChelsea ,first radio fun w/ graham norton at @BBC2Radio2



off to talk about our new Cambridge Algal Innovation Centre PHYCONET conference! CPI CambPlants Cam Botanic Comms



Just finished his keynote at the Association of Colleges (AoC) conference, Lord Sainsbury now seeing how #techniciansmakeithappen at stand 37 #AoCConf






Excellent piece in Chartered Institute of Horticulture magazine on the importance of #STEM STEM Learning Science, Tech, Eng & Maths for #Horticulture #LandSkills